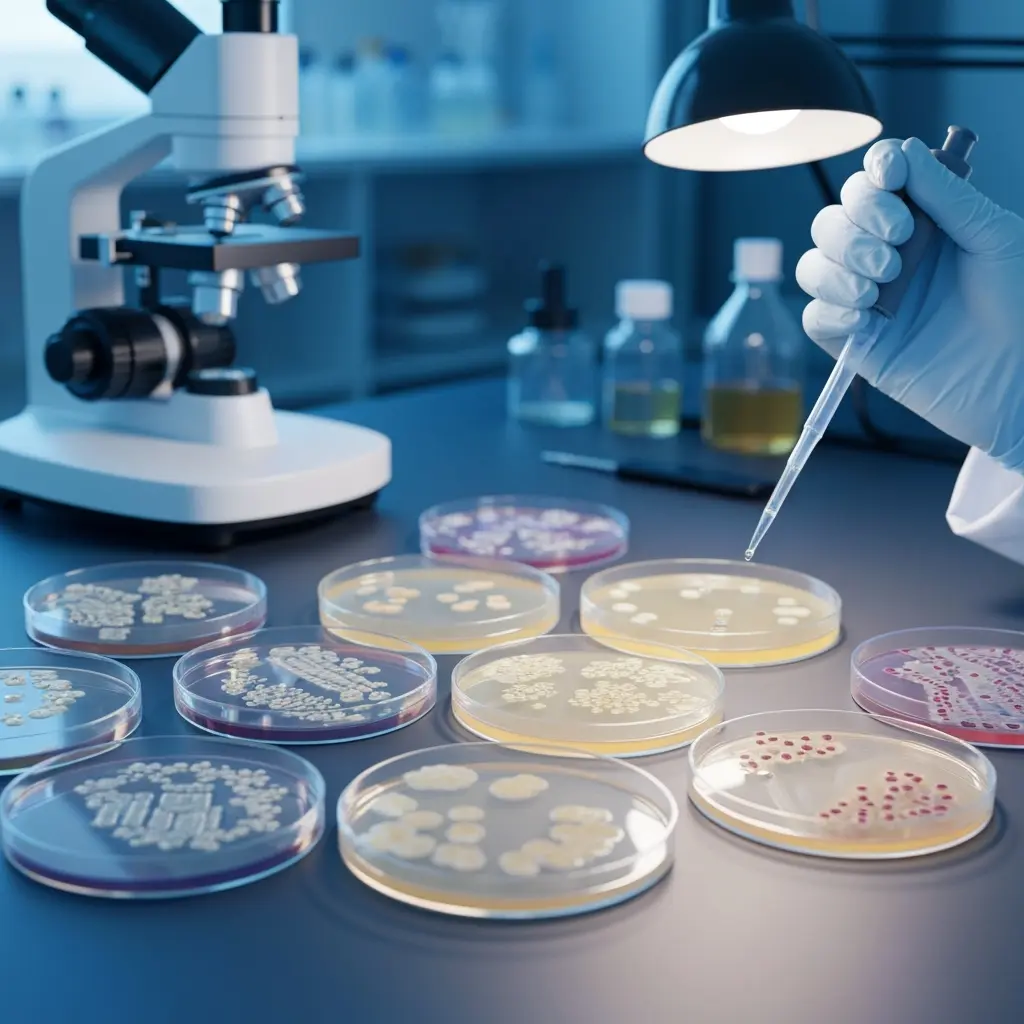

Safe, Reliable, and Comprehensive Microbiological Testing
Our Testing Capabilities
Microbiological Assurance You Can Trust
Microbiological safety is one of the most critical aspects of food and beverage quality. Contamination from bacteria, yeast, or molds can compromise shelf life, affect taste and texture, and most importantly, pose serious health risks. Our comprehensive suite of microbiological tests will assess the safety of these items, assisting you in eliminating harmful bacteria and avoiding safety recalls.
At Salalah Laboratories, we use internationally recognized methods to identify and quantify microorganisms in food, beverages, and raw materials. Whether you need to verify hygiene standards, validate product safety, or meet export regulations, our microbiological testing services provide the accuracy and assurance you can depend on.
We provide a wide range of microbiological testing services
Our Testing Capabilities
Tests
Enumeration Tests
These tests measure the total number of microorganisms present in a sample:
- Aerobic Plate Count (APC)
- Enterobacteriaceae
- Coliforms & Faecal Coliforms
- Escherichia coli
- Staphylococcus aureus
- Clostridium perfringens
- Pseudomonas spp
- Yeast & Moulds
- Bacillus cereus
- Sulfite Reducing Bacteria
- Legionella
- Lactobacilli spp
- Lactic acid bacteria

Tests
Pathogen Testing
Focused detection of harmful organisms that pose serious health risks:
- Salmonella spp
- Listeria spp
- Listeria monocytogenes
- Escherichia coli O157
- Campylobacter spp
- Campylobacter jejuni
- Vibrio spp
- Vibrio cholerae
- Vibrio parahaemolyticus
- Shigella spp
- Cronobacter sakazakii
- Enterococci
- Legionella spp
- Legionella pneumophila
Additional Services
01
Molecular Biology Testing
Pork DNA detection based on real-time polymerase chain reaction (RT-PCR) method.
Detection Of Lard DNA in Cosmetics and Personal Care Products
02
Environmental Monitoring
Using swab samples, contact plates, or settle plates to check hygiene in facilities.
03
Hand Swabs
Detecting Staphylococcus aureus and E. coli on food handlers.





Industries We Support
Dairy & Infant Nutrition
Milk, Flavored milk, Butter, cheese, yogurt, Milk Powder, baby food, and nutritional powders.
Beverages
Juices, soft drinks, bottled water, and other liquid products.
Meat, Poultry & Seafood
Fresh, processed, and canned meat, poultry, fish, and seafood.
Grains, Oils, Fats & Bakery
Cereals, flours, Cooking oils, baked goods. and related products.
Snacks, Sweets & Condiments
Packaged snacks, confectionery, spices, herbs, and flavoring agents.
Comprehensive Medical Services
Why ChooseSalalah Laboratories
-
1
Accreditation
ISO/IEC 17025:2017 accredited by GCC Accreditation Center -
2
Modern lab
Modern laboratory instruments and validated testing methods -
3
Local expertise
Local expertise combined with internationally recognised standards

Client Experiences
Trusted by
Leading Brands and Businesses
Salalah Labs’ microbiological testing gave us clear, detailed results that helped us pass a key export inspection. Their professionalism and speed made all the difference.
Aisha
Food Manufacturer
We needed urgent water testing for a government tender. Salalah Labs delivered accurate results within days, ensuring we met all compliance requirements
Fahad
Water Treatment Company
Their nutritional analysis reports are thorough and easy to understand, which helps us market our products with confidence.
Samar
Snack Brand Owner
Animal feed testing from Salalah Labs has been a game-changer for our quality control. They are consistent, transparent, and highly skilled.
Hasan
Feed Mill Owner
Frequently Asked Questions

Your Guide to
Common Questions
Learn more about who we are, how we work, and what makes our laboratory a trusted partner for businesses across Oman and the GCC.
How do I submit samples for testing?
You can deliver samples directly to our laboratory in Salalah or arrange for courier pickup. Our team will guide you on the correct sample quantity, packaging, and storage requirements.
How long does testing usually take?
Turnaround time depends on the type of test. Standard analyses are typically completed within a few working days, while specialized tests may require additional time.
Are your results accepted by regulators and international buyers?
Yes. Our laboratory is ISO/IEC 17025:2017 accredited by the GCC Accreditation Center, meaning our reports are internationally recognised and trusted.
Do you provide consultation on which tests are needed?
Yes. Our experts will help you identify the right testing methods based on your product type, compliance needs, and market requirements.
